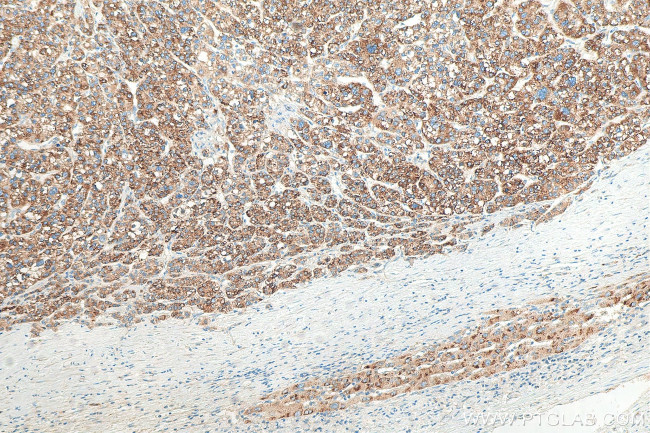
fetuin-B Antibody in Immunohistochemistry (Paraffin) (IHC (P))
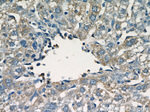
fetuin-B Antibody in Immunohistochemistry (Paraffin) (IHC (P))

Search
Proteintech
fetuin-B Polyclonal Antibody
{{$productOrderCtrl.translations['antibody.pdp.commerceCard.promotion.promotions']}}
{{$productOrderCtrl.translations['antibody.pdp.commerceCard.promotion.viewpromo']}}
{{$productOrderCtrl.translations['antibody.pdp.commerceCard.promotion.promocode']}}: {{promo.promoCode}} {{promo.promoTitle}} {{promo.promoDescription}}. {{$productOrderCtrl.translations['antibody.pdp.commerceCard.promotion.learnmore']}}
产品信息
18052-1-AP
种属反应
宿主/亚型
分类
类型
抗原
偶联物
形式
浓度
规格
纯化类型
保存液
内含物
保存条件
运输条件
产品详细信息
Immunogen sequence: QLALNPSAL LSRGCNDSDV LAVAGFALRD INKDRKDGYV LRLNRVNDAQ EYRRGGLGSL FYLTLDVLET DCHVLRKKAW QDCGMRIFFE SVYGQCKAIF YMNNPSRVLY LAAYNCTLRP VSKKKIYMTC PDCPSSIPTD SSNHQVLEAA TESLAKYKNE NTSKQYSLFK VTRASSQWVV GPSYFVEYLI KESPCTKSQA SSCSLQSSDS VPVGLCKGSL TRTHWEKFVS VTCDFFESQA PATGSENSAV NQKPTNLPKV EESQQKNTPP TDSPSKAGPR GSVQYLPDLD DKNSQEKGPQ EAFPVHLDLT TNPQGETLDI SFLFLEPMEE KLVVLPFPKE KARTAECPGP AQNASPLVLP P (23-382 aa encoded by BC074734)
靶标信息
The protein encoded by this gene is a member of the fetuin family, part of the cystatin superfamily of cysteine protease inhibitors. Fetuins have been implicated in several diverse functions, including osteogenesis and bone resorption, regulation of the insulin and hepatocyte growth factor receptors, and response to systemic inflammation. This protein may be secreted by cells.
仅用于科研。不用于诊断过程。未经明确授权不得转售。
篇参考文献 (0)
生物信息学
蛋白别名: 16G2; fetuin beta; fetuin phosphoprotein; Fetuin-B; Fetuin-like protein IRL685; Gugu; Gugu beta; Gugu gamma; Gugu-a; IRL685; unnamed protein product
基因别名: 16G2; 2310011O17Rik; AI255764; D17980; Fet; FETUB; Gugu; IRL685; Pp63
UniProt ID: (Human) Q9UGM5, (Mouse) Q9QXC1, (Rat) Q9QX79
Entrez Gene ID: (Human) 26998, (Mouse) 59083, (Rat) 83928